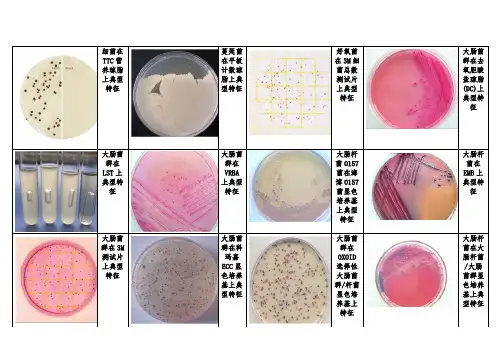

微生物图谱 (完全免费)
- 格式:doc
- 大小:6.85 MB
- 文档页数:8

污水处理常见微生物照片1、变形虫(阿米巴)amoeba.顾名思义,变形虫是能变形的。
不过这种变形也是有限度的。
一些种类的变形虫能向四外伸出假足,以探查水中的化学成分,决定移动方向。
而有些种类根本没有假足。
他们猎食时覆盖它的猎物,把猎物裹起来,这样就产生了一个食物泡,食物泡可以消化吸收猎物。
大多数变形虫对人体无害,但有几种变形虫能产生人类疾病:阿米巴痢疾,主要发生在贫穷国家。
变形虫食性广,单细胞藻类,细菌,小原生动物,真菌,有机碎片等皆是它们的食物.变形虫生命力强,在条件不好时,可以形成一个包囊(休眠体)度过难关.动态中的食物泡. 食物泡中充满了酶,用来消化猎物.消化过程很容易用显微镜观察。
food vacuole:食物泡nucleus:细胞核变形虫的尾末端结构,并非所有种类的变形虫都有尾末端,2、太阳虫目(Heliozoan)中间的圆形的东西是核,而细胞的外层部分有很多大的液泡。
两个太阳虫在分享一顿美食。
可是不久其中的一个让出了食物,然后他们两个分开来。
图 C 显示许多太阳虫个体组成了群体,进行捕食3、草履虫群居的草履虫受攻击的草履虫下面是草履虫的模拟图4、栉毛虫很像个小乌龟6、寡毛虫?7、线虫8、桡足虫9、钟形虫钟虫分裂中10、漫游虫Lionotus11、吸管虫Suctoria特征:带有几根细长的吸管12、固着型纤毛虫Peritricha13、游泳型纤毛虫Holotricha上面这张是生物接触氧化池填料上的微生物,应该是累枝虫吧!也有点象钟虫。
下面这张也是:15、喇叭虫污泥膨胀时的图片污泥膨胀时大量的菌丝伸出菌胶团,菌丝形状稍弯,无分枝,长度在50um~200um之间,直径在~之间,菌丝上有部分附着物,内有颗粒污泥凝结核菌胶团图片一个降解木质素的菌株亚硝化单胞菌废水中微生物,除了轮虫外,旁边可看到丝状菌大量繁殖厌氧颗粒污泥的照片来源:就要环保网。

污水处理过程中常见的微生物图谱微生物在污水处理厂生化系统调试、后期稳定运行和工艺调整过程中,起着很重要的指示作用,通过镜检活性污泥中的微生物状况,可以获得该活性污泥的相关性状信息,对生产起到一定的指导作用。
在活性污泥系统中,根据对活性污泥是否有利将原生动物分为非活性污泥类原生动物、中间性活性污泥类原生动物和活性污泥类。
1.活性污泥类原生动物活性污泥类原后生动物种类最多,其指标对活性污泥所处状态具有较高的参考价值,此类原后生动物作为优势种出现就可以认为此系统是较为成熟的活性污泥系统,处理效果较理想,常见的活性污泥类原后生动物有以下几种:1.1钟虫1)形态特点:若钟形,前端口围边缘较本体更宽阔,后端有钟柄具有伸缩性。
内质含有不少卵圆形的食物泡,往往带一些黄色。
2)活动特点:固着生长于菌胶团。
3)指示意义:在运行初期曝气池中大量出现钟虫时,表明活性污泥已成熟,充氧正常。
水中溶解氧含量适中时,钟虫很活跃;当溶解氧少于1mg/L时就不活跃,前端会出现一个大气泡(又有人发现溶氧过多时钟虫前端也会有大气泡)。
所以,钟虫前端出现气泡,往往说明充氧不正常,水质将变坏。
当钟虫口盘缩进、伸缩泡很大,细胞质空泡化、活动力差、畸形、接合生殖、有大量孢囊形成等现象时,即使虫数较多,也说明处理效果不好。
4)图例:图1图2图3领钟虫图4沟钟虫图5污钟虫图6八钟虫图7小口钟虫图8游泳钟虫图9长钟虫1.2累枝虫1)形态特点:虫体与钟虫相似,前端有膨大的围口唇。
群体,柄无肌丝而不收缩。
2)活动特点:固着生长,个别种营浮游生活。
3)指示作用:水质澄清良好、出水清澈透明时与钟虫、盖虫、轮虫等同时出现。
而在生活污水中累枝虫大量出现则是污泥膨胀、解絮的征兆。
4)图例:图1图2图3湖累枝虫(a)正常的双分叉形分枝;(b)不正常的双分叉形分枝;(c)杆柱形分枝;(d)收缩状态;(e)自然环境中分枝的双分叉型;(f)无恒型分枝图4瓶累枝虫图5浮游累枝虫(a)分枝的一部分(a)自然环境中群体分枝状态;(b)收缩的形态(b)活性污泥中分枝及伸展状态;(c)自然环境中个体伸展状态1.3三刺榴弹虫(又名板壳虫)1)形态特点:体呈榴弹形,外质硬化,体表由排列整齐的外质壳板围裹。

金黄色葡萄球菌革兰染色显示典型成簇的革兰阳性球菌。
金黄色葡萄球菌由金黄色葡萄球菌引起的败血症病人血培养的革兰染色。
炭疽芽胞杆菌吕弗勒多色亚甲基蓝染色。
炭疽芽胞杆菌的芽胞染成红紫色(多色亚甲基蓝,放大1000倍)炭疽芽胞杆菌/蜡样芽胞杆菌血琼脂培养,显示具有波状边缘的大的灰白色菌落。
各种腐生芽胞杆菌通常是溶血的。
炭疽有高度传染性,在实验室处理标本时要特别小心。
(血琼脂,18小时,37℃)大肠埃希杆菌,革兰染色染色显示肠杆菌科典型的革兰阴性杆菌。
大都有相似的形态,所以不能用革兰染色鉴别。
(革兰染色,放大1000倍)在麦康基培养基上培养的大肠埃希杆菌大肠埃希杆菌产生粉红色乳糖发酵菌落。
麦康基培养基是肠道细菌的选择培养基,含胆盐、乳糖和pH指示剂中性红。
乳糖发酵菌落产生酸,将指示剂变红。
(麦康基琼脂,18小时,37℃)患脑膜炎球菌脑膜炎病人脑脊液的革兰染色染色显示脑膜炎奈瑟菌为排列成对的革兰阴性双球菌,染成粉红色的为白细胞。
(革兰染色,放大1000倍)脑膜炎奈瑟菌巧克力琼脂培养在热血(巧克力)琼脂上,显示灰白色菌落,其氧化酶阳性。
(热血琼脂,18小时,37℃)霍乱弧菌碱性蛋白胨水培养革兰染色显示革兰阴性、逗号状的霍乱弧菌。
它们的特征性外形有助于霍乱的推测性诊断。
(革兰染色,放大1000倍)在碱性蛋白胨水中培养的霍乱弧菌室温6小时后,在气液交界面可见生长。
碱性蛋白胨水是用于可疑霍乱病例的粪便或直肠拭子的转移培养基。
(碱性蛋白胨水,6小时,室温)含有铜绿假单胞菌的痰液的革兰染色囊性纤维变性病人痰液显示葡萄球菌和铜绿假单胞菌、细的革兰阴性杆菌。
(革兰染色,放大1000倍)铜绿假单胞菌培养于麦康培养基,铜绿假单胞菌为非乳糖发酵菌,经常产生稍带绿色的绿脓菌素色素,其氧化酶阳性。
(麦康基琼脂,18小时,37℃)产气荚膜梭菌(魏氏梭菌)取自气性坏疽病人脓液的革兰染色,显示粗的砖形革兰阳性杆菌。
(革兰染色,放大1000倍)破伤风梭菌,革兰染色破伤风梭菌是细的末端有芽胞的革兰阳性杆菌。

微生物的鉴别与图谱第一篇微生物概述第一章微生物的形态结构第二章微生物的营养第三章微生物的生长第四章微生物的代谢第五章微生物的遗传变异第六章微生物的传染与免疫第七章微生物资源的开发与利用第二篇微生物分类与命名第一章微生物的分类单元第二章微生物的命名规则第三章细菌、放线菌、真菌的分类系统第三篇微生物鉴别技术与方法第一章微生物鉴别的条件第二章微生物鉴别的方法第三章查阅检索表进行定名第四章微生物鉴别的依据第五章微生物鉴别的技术与方法第四篇细菌的形态鉴别第一章细菌的大小鉴别第二章细菌的形态鉴别第三章细菌的特殊结构鉴别第四章细菌的化学鉴别技术第五篇病菌、真菌、支原体与衣原体鉴别方法第一章病菌的鉴别方法第二章真菌的鉴别方法第三章支原体的鉴别方法第四章衣原体的鉴别方法第六篇淡水微生物图谱第一章细菌图谱第二章放线菌图谱第三章真菌图谱第四章蓝细菌图谱第五章隐藻门图谱第六章金藻门图谱第七章甲藻门图谱第八章黄藻门图谱第九章裸藻门图谱第十章硅藻门图谱第十一章绿藻门图谱第十二章原生动物门图谱第十三章轮虫图谱第十四章枝角类微生物图谱第十五章桡足类微生物图谱第十六章其他微生物图谱第七篇微生物检测验证技术第一章微生物检测验证概述第二章微生物检测实验室的设施与设备验证第三章微生物检测用标准物质的使用及管理第四章消毒剂的使用及效力验证第五章培养基、缓冲液、稀释剂、淋洗液和试剂的验证第六章灭菌法第七章药品微生物检测方法的验证第八章微生物检测数据的趋势分析和统计处理第九章有关微生物检测的操作方法第八篇实验医学微生物鉴别技术第一章化脓性细菌鉴别技术第二章肠道感染性细菌鉴别技术第三章厌氧性细菌鉴别技术第四章呼吸道感染性细菌鉴别技术第五章动物原性细菌鉴别技术第六章螺旋体鉴别技术第七章支原体鉴别技术第八章立克次体鉴别技术第九章衣原体鉴别技术第九篇医学微生物鉴别及电镜图谱第一章呼吸道传播的病原微生物鉴别及电镜图谱第二章消化道传播的病原微生物鉴别及电镜图谱第三章创伤感染的病原微生物鉴别及电镜图谱第四章性传播的病原微生物鉴别及电镜图谱第五章接触感染的病原微生物鉴别及电镜图谱第六章输血及血制品传播的病原微生物鉴别及电镜图谱第七章节肢动物传播的病原微生物鉴别及电镜图谱第八章机会性感染的病原微生物鉴别及电镜图谱内容简介本书主要详细介绍了细菌、放线菌、病菌、真菌、支原体、衣原体、隐藻门类、金藻门类、甲藻门类,等等各种微生物鉴别技术、方法与图谱;以及医学各种微生物鉴别及电镜图谱。

微生物细菌(原核细胞)
分类
球菌(球形)
杆菌(杆形)
螺旋菌(螺旋形)
球/杆/弧/螺旋
结构
一般结构
没有成形的细胞核
没有核膜包被,核质裸露
核质
特殊结构
鞭毛有助于运动
荚膜
细胞壁外
具有保护作用
芽孢具有休眠作用
营养方式寄生/腐生
生殖方式分裂生殖
联系生活
好处
参与物质循坏(分解者)
黄色短杆菌味精
乳酸(杆)菌酸奶
甲烷菌沼气
坏处
结核杆菌肺结核
肺炎双球菌肺炎
真菌(真核细胞)
分类
单细胞酵母菌
多细胞
霉菌:青霉,曲霉
大型真菌:香菇,木耳,灵芝
结构
有核膜包被
细胞核
营养方式寄生/腐生
生殖方式
孢子生殖
出芽生殖(酵母菌)
生活环境
均有分布
潮湿/营养丰富→长得最好
联系生活
好处
食用:木耳,灵芝,猴头...
制药:生产抗生素,传统药材...
环保:促进自然界的物质循坏
坏处
疾病:脚癣
中毒:鬼笔鹅膏
病毒
分类动物病毒/植物病毒/细菌病毒(噬菌体)
结构
无细胞结构
蛋白质外壳,内部遗传物质
生活方式
不能独立生活
寄生
繁殖方式自我复制
联系生活
好处
疫苗
生物杀虫剂
坏处狂犬病,流感。
目录:病毒,真菌,厌氧菌,G+,G-,生化鉴定试验,药物敏感性试验病毒
被SARS病毒感染癌病毒T细胞表面的艾滋EB病毒抗原
丙肝病毒艾滋病病毒艾滋病病毒流感病毒
真菌
蓝色犁头菌纯培蓝色犁头菌在PD少根根霉在PDA上少根根霉纯培养黄曲霉产色平皿上的白白色念珠菌白色念珠菌申克孢子丝菌(双申克孢子丝菌(双少根根霉少根根霉新型隐球菌热带念珠菌热带念珠菌热带念珠菌
啤酒酵母菌啤酒酵母菌裴氏着色真菌裴氏着色真菌裴氏着色真菌裴氏着色真菌马尔尼菲青霉(双马尔尼菲青霉(双蓝色犁头霉蓝色犁头霉克柔念珠菌克柔念珠菌
卡氏支孢霉卡氏支孢霉桔青霉桔青霉
紧密着色真菌紧密着色真菌酵母菌黄曲霉黑曲霉黑曲霉光滑念珠菌光滑念珠菌
构巢曲霉构巢曲霉新型隐球菌新型隐球菌
白色念珠菌白色念珠菌白色念珠菌白色念珠菌紧密着色真菌酵母菌黄曲霉黑曲霉黑曲霉光滑念珠菌光滑念珠菌构巢曲霉构巢曲霉新型隐球菌新型隐球菌白色念珠菌白色念珠菌白色念珠菌白色念珠菌尤状瓶霉01尤状瓶霉02杂色曲霉01杂色曲霉02总状毛霉
厌氧菌
propionibacter厌氧消化链球菌双歧双歧杆菌破伤风梭菌乳杆菌肉毒梭菌艰难梭菌脆弱拟杆菌绳状青霉绳状青霉深红酵母菌01深红酵母菌艰难梭菌黑色消化链球菌脆弱拟杆菌产气夹膜梭菌产黑色素普雷沃不解糖卟啉单胞梭状芽孢杆菌乳酸杆菌
表皮葡萄球菌金黄色葡萄球菌β溶血性链球菌肺炎链球菌(α溶血菌落图片奴卡菌金黄色葡萄球菌炭疽杆菌血涂片化脓性链球菌肺炎链球菌衣氏放线菌炭疽杆菌串珠试炭疽杆菌炭疽杆菌荚膜形炭疽杆菌炭疽杆菌
炭疽杆菌炭疽杆菌炭疽病(呼吸道炭疽杆菌
葡萄球菌蜡样芽孢杆菌炭疽杆菌炭疽杆菌
放线杆菌葡萄球菌
副流感嗜血杆菌梭形芽孢杆菌枯草芽孢杆菌波斯坦芽孢杆菌矮小芽孢杆菌变形杆菌周身鞭浅黄假单胞菌产色素铜绿假单产色素铜绿假单产金黄色色素栖铜绿假单胞菌铜绿假单胞菌鼠伤寒沙门氏菌破伤风梭菌淋球菌霍乱弧菌
大肠埃希菌大肠埃希氏菌淋球菌鲍氏志贺菌
白色念珠菌和红衣原体细菌的鞭毛细菌L型菌落类型炭疽杆菌流感嗜血杆菌流感嗜血杆菌流感嗜血杆菌
流感嗜血杆菌流感嗜血杆菌淋球菌立克次体霍乱弧菌黄曲霉弧状菌铜绿假单胞菌L型大肠杆菌大肠杆菌大肠杆菌鲍氏志贺菌L型细菌油煎蛋样L型细菌L型细菌L型细菌
生化鉴定试验
触酶试验产气夹膜梭菌汹鼠伤寒沙门氏菌O-F实验马尿酸盐水解试触酶实验胆汁溶菌实验硝酸盐还原实验
枸橼酸盐利用试吲哚试验2吲哚试验1凝固酶实验(试
VP实验
药物敏感性试验
常规药敏图片常规药敏图片药敏试验图片大肠杆菌药敏图双纸片确证试验大肠杆菌双纸片大肠杆菌ESBL 筛大肠杆菌ESBL确苯唑西林耐药散苯唑西林和头孢ESBL 确证试验ESBL 确证试验D-试验(葡萄球DNA酶试验。